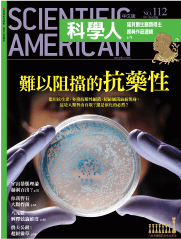

0%
2024 台灣科學人年會
Taiwan Science Forum

圓滿落幕!
參與年會
多元化的科學人
全方位帶領探索科學
2024/12/21(六)09:00-17:00
富邦國際會議中心 / B2 全廳區
|活動流程|
上午 08:30-12:10
下午 13:00-17:10

|購買方案|
|年會參與須知|
購票期限
晚鳥票:
即日起 ~ 12/13 23:59
(如售罄則提前結束)。付款方式
票券方案可採線上刷卡、ATM 轉帳、超商繳費,三種付款方式;若購買含訂閱之方案,僅可以線上刷卡方式結帳。
入場方式
繳費完成後,將收到購買成功信,並於活動前一週寄發入場 QR Code 至信箱,活動當天憑 QR Code 報到入場。
退票須知
票券退費須於 12/13(五)前,來信客服信箱申請辦理。
關於《科學人》
科學知識、資訊的閱讀目的十分多樣,從工作、考試到娛樂消遣都有,《科學人》內容自頂級期刊與科學家出發,透過適度的軟化、轉化,並以專業與懷疑精神,一字一句地為你挖掘、企劃出精選報導,將繁複的知識藉由深入淺出的文字,呈現給在乎正確性、專業度的你。
|台灣科學人見證的科學發展|
讀者回饋
謝謝
成為科學人的你們
數十年來,台灣科研人才在世界各地發光發熱,從宇宙學到生物學,幾乎每年都有許多發布到頂級期刊的科研成果與專利。 因為有繼續相信科學人的你,才讓科學人獲得邁步的動力,繼續為台灣見證與世界科學接軌的足跡!

2003 ~ 2019 年間,累積獲得《科學技術類》、《科普類》、《學習類》等各類獎項肯定

2024 年—蛻變之後第一年,睽違八年,再獲金鼎獎第 48 屆最佳學習類雜誌獎